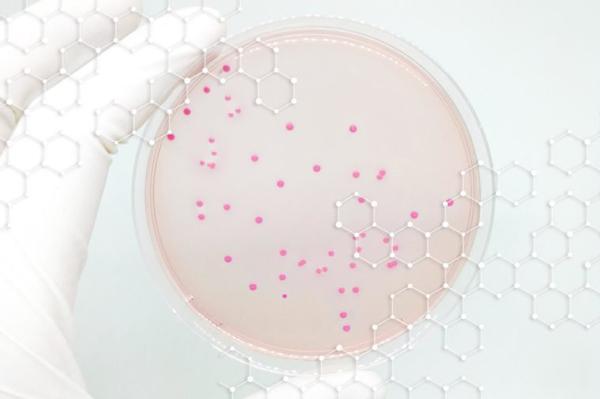

1. Dấu vân tay
Tất cả chúng ta đều biết rằng dấu vân tay của mỗi người là độc nhất và hoàn toàn khác nhau, thậm chí dù là cặp song sinh. Thế nhưng tại sao con người lại sở hữu đặc điểm này thì tới nay khoa học vẫn chẳng thể giải đáp.
Trong nhiều năm các nhà khoa học đã nghĩ rằng con người có dấu vân tay là để dễ cầm nắm mọi thứ. Nhưng hóa ra dấu vân tay thậm chí còn khiến da bạn khó tiếp xúc với các đồ vật hơn những ngón tay trơn nhẵn.

Điển hình của trường hợp không có dấu vân tay vẫn sinh hoạt bình thường và tay thậm chí còn nhanh nhạy hơn người khác chính là gia đình Hoàng Tiến gồm 60 người ở Đài Bắc mà tất cả các đầu ngón tay đều nhẵn bóng, không có vân tay. Năm 2008, các quan chức Cục điều tra hình sự CIB Đài Loan đã rất bất ngờ khi phát hiện ra điều đặc biệt của gia đình này. Lin Teih Bi, một chuyên gia về nhận dạng dấu vân tay của Đài Loan, đã xác định được gene di truyền không dấu vân tay của đại gia đình Hoàng Tiến trải qua ít nhất 5 thế hệ.
Ngoài giả thiết về cầm nằm thì còn có người cho rằng những dấu vấn tay là dấu vết của sự tiến hóa, giúp bảo vệ ngón tay hoặc tăng độ nhạy cảm.
2. Ruột thừa
Đây là bộ phận cơ thể có thể “ngấm ngầm” gây đau đớn bất chợt và dù không có nó thì cơ thể bạn cũng không gặp vấn đề gì. Ruột thừa được coi là cơ quan gây rắc rối hơn là hữu dụng. Đã có không ít người phải nhập viện để mổ ruột thừa. Một trường hợp mổ ruột thừa hiếm gặp trên thế giới đã đi vào lịch sự y khoa đó là ca tự phẫu thuật ruột thừa của bác sĩ Leonid Ivanovich khi đang ở Nam Cực. Sau 45 phút tự mổ dưới sự hỗ trợ của đồng nghiệp, bác sĩ trẻ đã thành công.

Lý giải về cơ quan thừa thãi này, trong nhiều năm, các nhà khoa học đều đồng ý rằng từ thời xưa con người ăn thực vật rất nhiều nên cần có ruột thừa để hỗ trợ tiêu hóa. Trải qua quá trình tiến hóa, nó dần trở nên vô dụng. Tuy nhiên một giả thiết khác đã trở nên phổ biến hơn trong cộng đồng khoa học cho rằng ruột thừa có thể chứa và bảo vệ các vi khuẩn có lợi.
3. Con người chỉ có thể thuận một tay
Chúng ta đều biết rằng mỗi người sinh ra sẽ có một tay thuận hoặc là bên trái hoặc là bên phải. Tuy nhiên có bao giờ bạn tự hỏi tại sao lại không thể thuận được cả hai tay? Chẳng phải điều đó sẽ giúp cơ thể vận động tốt hơn?
Đến nay đây vẫn là một bí ẩn lớn với khóa học và dù có người có thể sử dụng cả 2 tay như nhau nhưng vẫn chưa có lời giải thích thỏa đáng về điều này.

Họa sĩ thiên tài Leonardo da Vinci chính là người có khả năng thuận cả 2 tay. Ông có thể viết đồng thời cả hai tay, một tay ở trên và một tay ở dưới.
4. Ngáp ngủ
Chúng ta đã biết ngáp ngay từ khi còn nằm trong bụng mẹ và các nhà khoa học vẫn chưa thể giải thích chính xác tại sao con người lại ngáp.
Một số nhà khoa học cho rằng chúng ta ngáp để điều chỉnh nhiệt độ não bộ vì thiếu ngủ hoặc chán nản khiến cho nhiệt độ não bị giảm.
Ngoài ra có người lại nhận định chúng ta ngáp để làm tỉnh táo lại cơ thể vì nhịp tim có khuynh hướng tăng lên sau khi ngáp.

5. Nhóm máu
Nhóm máu cũng là “dấu tích” của sự tiến hóa. Các loại máu khác nhau có khả năng chống lại các bệnh nhiễm trùng khác nhau. Các nhà khoa học tin rằng nhóm máu của con người bắt đầu phát triển từ khoảng 20 triệu năm trước.
Tiến sĩ Mohammad Mobayed giải thích: “Quá trình tiến hóa đã tạo ra sự đa dạng về máu khiến cho mỗi người sở hữu nhóm máu khác nhau và có khả năng chống lại một số bệnh nhiễm trùng.”
“Tuy nhiên điều các nhà khoa học chưa thể biết đó chính là tại sao nhóm máu lại khác nhau ở mỗi người.” Ông nói.

6. Cơ thể người có vi khuẩn
Con người có rất nhiều vi khuẩn bên trong và trên cơ thể, chúng thậm chí còn chiếm một vài cân nặng trên người chúng ta. Nhiều vi khuẩn có ích cho sức khỏe như hỗ trợ hệ tiêu hóa, chữa lành vết thương hoặc chống lại bệnh tật.
Thế nhưng có không ít những vi khuẩn trong cơ thể mà chúng ta vẫn chẳng thế biết chúng được sinh ra với mục đích gì.
Theo Khám Phá
